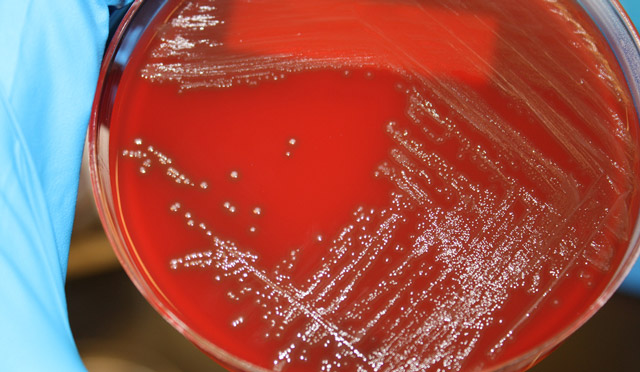

С трептококк представляет собой полезный, условно-патогенный или патогенный микроорганизм шарообразной формы (которую имеют все кокки). Эта бактерия относится к анаэробным, то есть для собственной жизнедеятельности она не нуждается в кислороде.
Подобный грамположительный патогенный агент считается весьма распространенным. Среднестатистический человек взаимодействует со стрептококком повсеместно, причем начиная с первых же дней жизни, а порой еще в утробе матери в перинатальный период.
Сами по себе стрептококки разнородны и делятся на несколько видов. Подобная гетерогенность приводят к возникновению нескольких классификаций этого микроорганизма. Было бы ошибкой утверждать, что все стрептококковые структуры опасны для здоровья. Некоторые из них обитают в кишечнике и оказывают благотворное влияние на пищеварительные процессы.
В целом же описываемый организм в большинстве своем опасен для здоровья и даже жизни. Стрептококк в горле всегда патогеннен. Наиболее часто встречается альфа-гемолитический микроорганизм (также называемый просто зеленящим), негемолитические структуры (гамма-типа), а также бета-гемолитические стрептококки (самые опасные).
Кратко об опасности стрептококковых структур
Описываемые патогенные агенты в горле опасны во всех случаях и от них нужно как можно быстрее избавляться.
Причин тому несколько:
- Гемолитические структуры способны растворять ткани и клетки крови (гемо — кровь, лизис — растворять). Это прямой путь к нарушениям гематологического профиля. Поскольку стрептококк разносится по всему организму, можно ожидать генерализованного поражения кровеносной системы. Процесс сопровождается разрушением эритроцитов и выбросом большого количества гемоглобина (патогномоничный признак).
- Стрептококковые агенты способны быстро разноситься по организму с током крови и лимфы. Это обуславливает возможность поражение отдаленных тканей и органов. Помимо классических инфекций верхних дыхательных путей, описываемые организмы способны провоцировать пневмонии, острые бронхиты, абсцессы, поражения желудочно-кишечного тракта, нарушать работу сердца (многим известен тезис, что кариозные зубы и больное горло вредят сердцу, это правда «благодаря» стафилококку).
- Альфа- и тем более бета-гемолитические стрептококки способны сопротивляться многим антибиотикам и адаптироваться под меняющиеся условия. Подобная резистентность обуславливает сложности в лечении. Прежде, чем назначать курс терапии нужно точно определить чувствительность флоры к антибактериальным средствам. Лечить «на глаз» бесполезно и даже вредно.
Стрептококковая инфекция горла часто сравнивается с поражением золотистым стафилококком. Если рассматривать второй микроорганизм — он определенно сложнее с точки зрения борьбы, к тому же более агрессивный. Но вызывает в большей мере гнойные процессы.
Стрептококк же чаще провоцирует проблемы с кровеносной системой. Хотя и тот и другой агенты относятся к пиогенной (гноеродной) флоре. Многие заболевания, спровоцированные стрептококками, протекают в латентной, скрытой либо вялой форме. Это усложняет диагностику.
Причины появления стрептококка в горле
Поражения горла и верхних дыхательных путей не возникают, что называется, «на пустом месте».Требуется сочетание сразу нескольких факторов.
Первая группа касается так называемых триггерных причин, которые запускают патологический процесс. Основной спусковой фактор один — это снижение местного (на уровне глотки) и общего иммунитета.
Какие же моменты влекут за собой снижение интенсивности работы защитной системы организма:
- Неправильное, несбалансированное питание. Алиментарный фактор является едва ли не основным в деле снижения защитных сил тела. Рекомендуется правильный рацион, с высоким содержанием витаминов, цитаминов, минеральных веществ. Проще говоря, как можно больше чистого белка, продуктов растительного происхождения и как можно меньше жирного, жареного, соленого, копченого и т.д.
- Глистные инвазии. «Перетягивают» внимание иммунитета на себя. Наиболее опасны описторхисы, эхинококки. Это смертельно опасные организмы.
- Нарушения питания младенцев. Как показывает практика, плохо сказываются на иммунной системе новорожденного позднее прикладывание к груди, раннее отнятие от молочных желез, перевод на искусственное вскармливание. Причина одна — в материнском молоке содержится большое количество естественных, уникальных иммуномодуляторов. Все описанные действия вредят молодому организму. Это нужно иметь в виду, планируя рацион в раннем возрасте.
- Гиповитаминоз. Авитаминоз. Иными словами — недостаток витаминов. Входит в структуру алиментарного фактора.
- Оперативные вмешательства. Операции тяжело сказываются на состоянии всего организма.
- Прием цитостатиков в рамках химиотерапии раковых заболеваний. Цитостатики угнетают выработку активно делящихся клеток, к которым относятся Т-лимфоциты и лейкоциты. Такие больные буквально беззащитны перед стрептококком.
- Прием антибиотиков, особенно длительный и бесконтрольный. Принимая препараты данной группы, пациент рискует не только здоровьем, но и жизнью.
- Трансплантация органов, сопровождающаяся приемом иммунодепрессантов. Эти препараты искусственно угнетают защитную систему организма, чтобы тело не отторгало пересаженный орган.
- Поражения печени терминального характера. Особенно цирроз, токсический и иной некроз гепатоцитов.
- Протеинурия (выделение жиров с мочой). Таким способом организм выводит избыток иммуноглобулинов. Встречается при заболеваниях, вроде почечной недостаточности.
- Хронические инфекционные поражения любой анатомической структуры тела. Перетягивают внимание иммунитета на себя, что позволяет новым микроорганизмам размножаться.
- Злоупотребление алкогольными напитками.
- Табакокурение . Особенно сильно сказывается на организме женщины.
- Стрессовые ситуации длительного характера. Интенсивные физические нагрузки. Одним словом — факторы выработки избыточного количества кортикостероидов, норадреналина, адреналина и кортизола. В группе особого риска пациенты с синдромом Иценко-Кушинга.
Как передаются микроорганизмы
Стрептококк встречается почти у 100% людей взрослой популяции. Распространенность агента определяется числом в 98-99%. Откуда такие цифры?
Все дело в вирулентности (способности заражать) этого микроорганизма. Инфекция способна поражать потенциального носителя несколькими способами. Каждый из них имеет место в повседневной жизни.
- Воздушно-капельный путь. Патогенные структуры выходят в окружающую среду с частичками слизистого секрета (слюны, слизи) при чихании, кашле, даже просто дыхании. Воздушно-капельный путь является основным в деле передами микроорганизма. Учитывая, какое количество людей инфицировано, нетрудно просчитать вероятность встретиться с носителем стрептококка. Не рекомендуется находиться с такими людьми в одном закрытом помещении.
- Контактно-бытовой путь. Это любые контакты с людьми неполового характера: рукопожатия, поцелуи (в особенности, поскольку стрептококк обитает в основном на слизистых). Также взаимодействие с предметами быта больных людей. Передача агентов возможна через игрушки, предметы гигиены, медицинские инструменты (встречается и такое, если врачи не соблюдают правила гигиенической обработки). Наиболее часто дети встречаются со стрептококком прямо при рождении, заражаясь от инфицированного медицинского персонала родильных домов.
- Пылевой путь. Встречается несколько реже. Проникновение патогенных агентов возможно с частичками домашней пыли, слущенной кожи, кусочками ткани. Особенно рискуют работники текстильных предприятий, офисов.
- Орально-генитальный путь. Любители орально-генитальных контактов находятся в опасности. Стрептококк обитает на слизистых оболочках, в том числе и половых органов. Совет один — тщательно предохраняться и не рисковать.
- Перинатальный путь. Стрептококковая флора без особых трудностей преодолевает плацентарный барьер и проникает в организм ребенка. Происходит это еще в утробе инфицированной матери. Потому уже во время планирования беременности рекомендуется пройти курс лечения. Излечить стрептококк целиком нельзя, но вполне возможно его угнетение и перевод в латентную, «спящую» фазу.
Высока вероятность транспортировки патогенного организма при наличии алиментарного фактора (например, при несоблюдении правил гигиены и употреблении пищи немытыми руками). В каждом случае нужно разбираться отдельно.
Какие симптомы ощущает больной?
Все зависит от характера патологического процесса. Локализованный в горле стрептококк вызывает несколько болезней:
В подавляющем большинстве случаев речь идет о воспалении небных миндалин — тонзиллите, который также называется ангиной. Симптомокомплекс весьма вариативен.
Клиническая картина включает в себя следующие проявления:
- Интенсивный болевой синдром. Дискомфорт имеет жгучий, ноющий тянущий характер. Гортань сильно саднит, возникает желание механически воздействовать на пораженный участок. Боли усиливаются при приеме пищи, употреблении холодной воды. Интенсивность ощущения несколько снижается при приеме теплого питья.
- Нарушения дыхания. Дышать становится тяжелее. Развивается одышка (увеличение числа дыхательных движений в минуту). Подобное наблюдается по причине отека горла. Воздуху становится труднее проходить. Это крайне опасный симптом, с которым нужно немедленно обращаться к врачу. Возможно удушье, асфиксия и смерть больного. Особенно вероятен подобный сценарий у детей.
- Отделение гнойного экссудата из горла. Гной может быть жидким: желтоватый или зеленоватый экссудат с резким неприятным запахом. Возможно формирование особых гнилостных сгустков, так называемых пробок. Это также желтоватые комочки резким запахом. Отделение подобного рода экссудата — прямое указание на наличие в горле гноеродной флоры, стрептококков или стафилококков.
- Формирование специфических беловатых пятен в горле. Обнаружить их может и сам больной при визуальной оценке зева. Пятна располагаются в случайном порядке, выглядят как налет.
- Кашель. Возникает из-за сильного першения в горле.
- Повышение температуры тела до фебрильных отметок и выше.
- Признаки общей интоксикации организма: головные боли, тошнота, рвота, слабость, разбитость и сонливость.
Подобные проявления быстро стихают, что нехарактерно для стафилококкового поражения. Симптомы, однако, остаются, хотя и в более мягкой форме. Это и есть латентная или хроническая фаза течения стрептококкового поражения горла.
Фарингит дополнительно проявляется сильным кашлем, нарушениями голоса. Однако встречается подобная болезнь сравнительно редко (примерно в 3-5% клинических случаев стрептококк дает о себе знать подобным образом).
Как проходит обследование?
Диагностикой стрептококковой инфекции горла занимаются специалисты по отоларингологии (ЛОР-врачи).
На первичном приеме необходимо собрать анамнез (выявить, чем болел или болеет пациент), определиться с характером жалоб, зафиксировать представленные данные. В дальнейшем это поможет. Верифицируют (подтверждают) диагноз с помощью лабораторных исследований.
Их список следующий:
- Серологичесский анализ. Существует несколько методик. Дает возможность отграничить одни микроорганизмы от других.
- Взятие мазка из зева с дальнейшим посевом биоматериала на питательные среды (бактериологическое исследование). Помогает выстроить верную терапевтическую модель и определиться с чувствительностью стрептококка к антибиотикам.
- Общий анализ крови. Дает картину воспаления со смещением лейкоцитарной формулы в сторону увеличения, ускорением оседания эритроцитов. Также косвенно на стрептококковую инфекцию, как уже было сказано, указывает повышение концентрации гемоглобина.
В дополнение проводится визуальная оценка горла. Обнаруживаются классические визуальные признаки тонзиллита: гиперемия горла, рыхлая структура тканей, беловатый или желтоватый налет и др.
В системе указанных обследований вполне достаточно для постановки диагноза и подбора правильного лечения.
Какова норма стрептококка?
Нормальные показатели стрептококка составляют 10 в 3 — 10 в 5 степени КОЕ/мл. Такое количество обитает на слизистых оболочках носоглотки большинства людей.
Все показатели выше 10 в 6 степени КОЕ/мл. рассматриваются как патология. Лечение требуется лишь когда бактерия становится причиной заболевания. Если же норма превышена, а симптомы воспаления отсутствуют — терапия не требуется.
Местные и системные антибиотики
Для лечения стрептококков в горле широко используются антибиотики. Применяются в форме растворов и таблеток соответственно. Могут быть назначены антибактериальные средства сразу нескольких групп (но не одновременно):
- Пенициллины. Как ни странно, порой стрептококк чувствителен к пенициллиновому ряду, чего не скажешь о золотистом стафилококке.
- Макролиды. Азитромицин или Эритромицин.
- Фторхинолоны. Используются в крайних случаях.
- Цефалоспорины. Назначаются в случае непереносимости пенициллинов, так же в случае нечувствительности к ним микроорганизмов.
В некоторых случаях оправдано применение тетрациклинов. Но они дают массу побочных эффектов, потому назначают подобные лекарства с осторожностью.
Предпочтение отдается местным антибиотикам, (таким как Гексорал, Себидин, Ринза Лорсепт) поскольку они производят таргетированный (целенаправленный) эффект и напрямую контактируют со стрептококком в горле.
Если поражение генерализированное (обширное), не обойтись без системных антибактериальных препаратов (в форме таблеток). При осложненной форме, лекарства используются в форме внутримышечных инъекций. Общая продолжительность курса лечения составляет от 7 до 14 дней.
Антисептические полоскания
Способствуют быстрому уничтожению патогенных структур, причем любого типа, в том числе позволяют эффективно вывести стрептококк из горла.
Наиболее эффективны следующие препараты:
- Хлоргексидин;
- фурацилин;
- Мирамистин (первоначально использовался против половых инфекций, но ему нашлось место и в отоларингологии).
Иммуномодулирующие препараты
Помогают выработке естественного интерферона, Т-лимфоцитов и лейкоцитов. Применяются такие препараты, как Имудон и аналоги, ИРС-19, Виферон, Интерферон и другие.
Прочие лекарства
Широко используются противовоспалительные нестероидного происхождения (Кетопрофен, Найз, Ибупрофен и его аналоги), кортикостероиды (Преднизолон).
При интенсивном зуде показаны антигистаминные средства третьего поколения (Цетрин и его аналоги). При острых состояниях — первого поколения (Пипольфен, Димедрол).
Возможные осложнения
Гноеродная флора дает множество осложнений. Среди них:
- менингит. Воспаление мозга;
- гломерулонефрит;
- отит;
- фарингит;
- артрит;
- пневмония;
- бронхит.
Перечень можно дополнить еще 20-30 наименованиями. Стрептококк может спровоцировать инфекционное поражение любой системы организма. Кроме того, возможна хронизация процесса.
Стрептококк — опасный сосед, который, однако, встречается почти у каждого. Его нужно держать в узде. В противном случае последствия могут оказаться непредсказуемыми. Лечение стрептококка в горле — прерогатива врача. Самолечение недопустимо.
Streptococcus mitis — микроорганизм из группы зеленящих стрептококков, образующих на кровяном агаре альфа-гемолиз. Он является нормальным обитателем ротовой полости и приобретает болезнетворные свойства лишь при определенных условиях. Стрептококк митис в горле продуцирует факторы патогенности и вызывает развитие фарингита. Это наиболее частая форма патологии ЛОР-органов стрептококковой этиологии.
Стрептококк получил название зеленящий, потому что он не полностью разрушает эритроциты. Streptococcus mitis постоянно присутствует во рту здорового человека. Нормальное функционирование иммунной системы сдерживает размножение микробов. Они мирно сосуществуют с макроорганизмом и называются потенциально-патогенными. При снижении общей сопротивляемости к инфекциям происходит активное размножение этих бактерий, возникают воспалительные явления в глотке.
- Кариес – под воздействием молочной кислоты и бактерий происходит деминерализация зубов.
- Пульпит – воспаление зубной пульпы развивается при локализации S. mitis в щелях между десной и поверхностью зуба.
- Заболевания ЛОР-органов — фарингит, тонзиллит, синусит возникают чаще всего.
- Эндокардит — микротравмы слизистой рта, обусловленные стоматологическими манипуляциями или банальной чисткой зубов, являются входными воротами для инфекции. Бактерии попадают в системный кровоток и оседают на эндокарде, взывая его воспаление.
- Зеленящие стрептококки в составе смешанной инфекции обнаруживают при менингите, воспалении легких, абсцедировании мозговой и печеночной ткани, сепсисе.
Возбудитель поражает одинаково часто организм взрослых людей и маленьких детей.
Чтобы правильно лечить инфекцию, необходимо выявить ее возбудителя. Для этого проводят микробиологическое исследование биоматериала, взятого от больного. После определения рода и вида микроорганизма ставят тест на чувствительность к антибиотикам. Лечение любой инфекции, в том числе и стрептококковой, этиотропное. Кроме антибиотиков больным назначают симптоматическую терапию, подобранную врачом с учетом индивидуальных особенностей организма.
Этиология
streptococcus mitis под микроскопом
Streptococcus mitis — грамположительные неподвижные бактерии сферической формы, располагающиеся в мазке цепочками. Они входят в группу зеленящих стрептококков, благодаря способности окрашивать среды с кровью в зеленый цвет, то есть образовывать на кровяном агаре альфа-гемолиз.
Стрептококк митис вне организма человека быстро погибает. Его можно легко уничтожить с помощью антисептиков, антибиотиков и ультрафиолета. При снижении иммунитета микроб приобретает болезнетворные свойства, обусловленные способностью продуцировать ферменты патогенности.
Streptococcus mitis – клинически значимый вид, который при активизации проникает в кровь и вызывает воспаление эндокарда. Зеленящие стрептококки легко передаются от человека к человеку и требуют обязательного лечения при наличии явной клиники недуга.
Для роста стрептококка в лабораторных условиях необходимы особые условия — наличие крови или сыворотки в питательных средах. На кровяном агаре вырастают мелкие серые колонии с зонами неполного просветления – альфа-гемолизом, в бульоне образуется придонный и пристеночный рост с крошковатым осадком. Бактерии расщепляют сахара с выделением кислоты, а также некоторые аминокислоты.
Эпидемиология
Streptococcus mitis проникает в организм пероральным путем. Бактерии в норме обитают в полости рта здоровых людей, не вызывая развития патологий. Носители инфекции, не имея никакой клинической симптоматики, могут заражать окружающих людей. Когда бактерии выходят из-под контроля иммунной системы, развивается воспалительный процесс.
- Долгая и высокодозная химиотерапия при онкопатологии,
- Активная антибиотикотерапия,
- Частые воспалительные заболевания ЛОР-органов,
- Регулярный прием антацидов,
- Глубокая нейтропения,
- Пересадка костного мозг,
- Несоблюдение правил личной гигиены,
- Переохлаждение организма,
- Курение,
- Травматическое повреждение слизистой оболочки ротовой полости,
- Герпес-вирусы,
- Гормонотерапия,
- Иммунодефицит.
Стрептококк митис чаще активизируется после переохлаждения осенью или весной.
Распространение инфекции происходит аэрогенным механизмом, который реализуется воздушно-капельным путем, и контактно-бытовым механизмом, который реализуется контактным и половым путями. Возможно самоинфицирование — миграция возбудителя в горло из воспаленных пазух при наличии гайморита.
Клиническая картина
Инфекционное поражение горла проявляется местными и общими признаками.
покраснение и отек слизистой горла
К первой группе относятся — покраснение и отек слизистой, гипертрофия миндалин, покрытых гноем, першение и боль в горле, изменение голоса, увеличение регионарных лимфоузлов. Сухой мучительный кашель — один из основных клинических признаков, с которым больные обычно обращаются к врачу.
Проявлениями интоксикационного синдрома являются: лихорадка, общее недомогание, быстрая усталость, познабливание, цефалгия, миалгия и артралгия, потеря аппетита. Общие симптомы инфекции у больных детей – капризы, плач, раздражительность, плохой сон, беспокойство, отказ от еды.
Симптомы патологии одинаковы у взрослых и детей. Если клинические признаки отсутствуют, а в мазке из зева обнаруживают зеленящего стрептококка, лечение не требуется. Мирно сосуществующие бактерии не представляют опасности и не должны вызывать панику. Чтобы избежать дальнейших неприятностей, необходимо постоянно укреплять иммунитет и вести здоровый образ жизни.
Диагностика
Самым информативным методом диагностики заболеваний, вызванных Streptococcus mitis, является бактериологический. Исследуют в микробиологической лаборатории отделяемое зева, кровь, мокроту и прочие выделения из очагов поражения. Диагностирование также включает выявление основных симптомов и проведение общего анализа крови. Все полученные результаты обязательно подтверждаются культуральным методом.
Стерильным ватным тампоном отбирают материал с миндалин и дужек больного. В течение двух часов необходимо произвести посев на стандартные питательные среды с сывороткой или кровью. После суточной инкубации посевов их просматривают и изучают характер роста. Для стрептококков данной группы характерны мелкие круглые серые колонии, окруженные зоной зеленоватого гемолиза. Подозрительные колонии снимают, микроскопируют и определяют их морфологические и тинкториальные свойства. Затем проводят более подробную идентификацию. Определив биохимические и серологические свойства микробов делают вывод о видовой принадлежности данного микроорганизма. В завершении ставят тест на чувствительность к антибиотикам.
Экспресс – диагностика проводится с помощью ПЦР – в слюне больных обнаруживают генетический материал Streptococcus mitis.
Лечебный процесс
Лечение заболеваний, вызванных Streptococcus mitis, направлено на предупреждение осложнений, которые могут развиться на 5-6 сутки. При отсутствии адекватной терапии бактерии проникают в кровь, распространяются по всему организму и вызывают развитие серьезных осложнений – менингита, воспаления легких, среднего уха. Длительность лечения зависит от тяжести заболевания и времени заражения.
- Зеленящие стрептококки чувствительны к пенициллинам. До определения чувствительности возбудителя больным назначают «Амоксиклав», «Амоксициллин», а также препарат из группы гликопептидов – «Ванкомицин». Длительность их использования обычно составляет 7-10 дней.
- Кроме перорального приема антибиотиков назначают и местные процедуры — рассасывания пастилок и леденцов, полоскания рта антисептиками и настоями лекарственных трав, орошение слизистой зева спреями для горла.
- Иммуномодулирующая терапия — для укрепления местного иммунитета используют «Имудон», «Лизобакт».
- Для восстановления кишечной микрофлоры применяют синбиотики – «Линекс», «Хилак форте».
- Больным рекомендован в лихорадочном периоде полупостельный режим, щадящее питание, употребление достаточного объема жидкости, укрепление иммунитета.
При необходимости назначают дезинтоксикационные и антигистаминные средства – «Энтеросгель», «Цетрин».
- Жаропонижающим действием обладают НПВС – «Нурофен», «Ибуклин».
- Для снятия признаков отравления организма рекомендуется пить не менее трех литров жидкости в день, полоскать нос и рот физраствором.
- При заложенности в носу применяют сосудосуживающие капли – «Ксилометазолин», «Отривин».
Если симптомы патологии игнорировать и не лечить инфекционное воспаление горла, могут развиться тяжелые осложнения на сердце, почки и другие органы.
По мере стихания острых признаков воспаления подключают физиотерапевтические процедуры. Больным показано УФО, электрофорез с хлоридом кальция, ингаляции. Физиопроцедуры улучшают приток крови к органам и стимулируют выздоровление.
Средства народной медицины, облегчающие симптомы стрептококковой инфекции:
иммуностимулирующим действием обладают цитрусовые, шиповник, клюква, киви, петрушка, смородина;
Абрикосовая мякоть снимает воспаление и восстанавливает слизистую горла;
- Репчатый лук и чеснок — природные антибиотики и антисептики;
- Полоскания горла настоем череды, ромашки, календулы помогут справиться с явлениями фарингита;
- Полоскания горла свекольным соком с яблочным уксусом;
- Настой хмеля и отвар репейника для приема внутрь;
- Лук, малина, чеснок, морковь, отвары трав — природные источники витаминов и микроэлементов.
Народные средства не могут заменить прием антибиотиков. Перед их применением необходимо проконсультироваться с врачом. Эти дополнительные методы лечения стрептококковой инфекции следует брать на вооружение.
Профилактика
- Закаляться,
- Заниматься спортом,
- Не курить и не пить,
- Содержать в чистоте тело и жилище,
- Избегать переохлаждений и сквозняков,
- Высыпаться,
- Соблюдать оптимальный режим труда и отдыха.
Streptococcus mitis — условно-патогенный микроорганизм, который обитает в ротовой полости и мирно уживается с огромным количеством других бактерий, активно заселяющих данный локус. При снижении защитных сил организма стрептококк митис становится патогеном, вызывающим острые инфекционные заболевания горла — фарингит или тонзиллит. Больные с першением и болью в горле, интоксикацией и сухим кашлем должны как можно скорее обратиться к врачу.
Видео: презентация на тему Streptococcus mitis
Люди с самого рождения начинают взаимодействовать с окружающей средой. В ней находится много различных бактерий. Без них наше существование было бы напрасным. Бактерии не всегда несут опасность для человека. Но при ослаблении иммунной функции начинают развиваться различные болезни. К одному из типов бактериальной инфекции относится стрептококк. Что это такое и насколько он опасен для окружающих?
Понятие о стрептококке
Стрептококковая инфекция горла является самой распространенной группой заболеваний. Бактерии могут располагаться на бытовых предметах, кожном покрове, слизистых оболочках и в пищеварительной системе.
Стрептококк пиогенный в горле может привести к разрушению кровяных клеток. Вследствие этого у пациента развиваются недуги в виде:
- заболеваний дыхательной системы;
- абсцессов и фурункулов;
- воспалений во внутренних органах;
- сепсиса.
Выделяют и негемолитические типы стрептококков. К примеру, зеленящий митис живет в ротовой полости и ведет к проявлению кариеса на зубах. А вот зеленящий вириданс располагается на слизистых оболочках. Но при этом не относится к патогенной флоре.
Причины возникновения стрептококка в горле

У взрослых людей причинной активирования стрептококков является наличие пагубных привычек. Такой процесс ведет к травмированию слизистой оболочки ротовой полости, из-за чего она становится более восприимчива к различным заболеваниям. К размножению стрептококков также может привести:
- постоянная изжога, то есть забрасывание желудочного сока в пищевод и глотку;
- иммунодефицитное состояние;
- длительный прием кортикостероидных медикаментов;
- химиотерапия.
Сложно избавиться от тех стрептококков, которые попали в организм в условиях стационара. Такие бактерии имеют сильную устойчивость к антибактериальным средствам, а потому приглушить их гораздо сложнее.
Стрептококк у новорожденного возникает вследствие заражения от матери во время родовой деятельности. Гемолитический стрептококк группы В является составляющей половой сферы у женщин. Их количество нередко увеличивается в период вынашивания. Вероятность заражения увеличивается при затяжной родовой деятельности, преждевременном разрывании плодных оболочек.
Заболевания, вызываемые стрептококком
Тонзиллит острого характера или ангина
Воспалительный процесс возникает в области миндалин. При ослабленной иммунной функции бактерии начинают активно размножаться, в результате чего появляется гнойное содержимое. Токсические вещества попадают в кровь, из-за чего поднимается температура, ослабленность и ломота в теле.
При стрептококковой инфекции в горле воспалительный процесс распространяется на соседние органы. Тогда принято говорить о развитие осложнений в виде отита, паратонзиллярного абсцесса, глоумерулонефрита, суставного ревматизма.
Фарингит
Воспалительный процесс в глоточной области, который поражает небные дужки, язычок и лимфатические фолликулы. Заболевание проявляется вследствие проникания патогенного стрептококка или при ослабленности иммунной функции. В данном случае воспаление имеет нисходящий характер, то есть бактериальная инфекция спускается в трахею и бронхи.
Признаки фарингита кроются в:
- першении в горле;
- болезненном чувстве во время глотания;
- кашле;
- незначительном повышении температурных показателей.
Фарингит не сильно влияет на общее состояние пациента. Но при отсутствии лечения может привести к развитию паратонзиллярного абсцесса, ларингита и трахеита.
Скарлатина
В детском возрасте все протекает гораздо тяжелее. К основным симптомам относят:
- повышение температурных показателей;
- сильную ослабленность и общее недомогание;
- высыпания по всему телу.
При несвоевременном лечении заболевание ведет к осложнениям в виде воспалительного процесса в лимфатических узлах, отита, аутоиммунных болезней, эндокардита, миокардита, нефрита и артрита.
Пародонтит
Воспалительный процесс наблюдается в пародонте, который располагается вокруг пораженного зуба. Стрептококковая инфекция нередко живет в десневых карманах. При понижении иммунной функции бактерии начинают активно размножаться. К такому процессу может привести некачественная гигиена, наличие кариозных образований, стоматит.
Пневмония
Если активно размножается стрептококк, пневмония в горле ведет к поражению легочной ткани, бронхов, крови и лимфы. Воспалительный процесс быстро спускается в легкие, в результате чего происходит нарушение газообмена и нехватка кислорода.
К основным признакам болезни принято относить:
- одышку;
- развитие лихорадочного состояния;
- ослабленностью;
- сильным кашлем.
Дети грудничкого возраста очень тяжело переносят стрептококковую пневмонию. Тяжелейшие формы пневмонии встречаются у пациентов с сильной ослабленной иммунной функцией или при отсутствии восприимчивости к антибиотикам.
Негемолитический или зеленящий стрептококк располагается в ротовой полости и занимает около шестидесяти процентов из всей микрофлоры. Кроме области горла зеленящий вид бактерий может поселиться в кишечной полости, а также привести к кариозным образованиям и эндокардиту.
Диагностирование заболеваний спровоцированных стрептококком
Перед тем как назначить лечебный процесс, доктор должен взять мазок из горла на анализ. Это нужно для того, чтобы отличить стрептококк от золотистого стафилококка. Полученная среда при помощи мазка подвергается лабораторной культивации. После этого специалисты изучают колонии и подсчитывают их количество. Также выполняется тест на восприимчивость инфекции к антибиотикам. Результаты анализа станут известны только через пять дней.
Но острый процесс не всегда заставляет себя ждать. Так как стрептококковая инфекция имеет повышенную восприимчивость ко всем антибиотикам, то лечебные мероприятия назначаются сразу.
Лечение стрептококковой инфекции в горле
Как лечить от стрептококка детей и взрослых? Первым делом необходимо обратиться к специалисту, который проведет экспресс-диагностирование для определения возбудителя болезни. Если у пациента обнаружен зеленящий стрептококк в горле, лечение заключается в устранении первопричины, которой могут выступать плохо вылеченные зубы или осложнения в виде эндокардита.
Также лечение стрептококковой инфекции в горле подразумевает употребление антибиотиков из пенициллиновой группы в виде Аиоксиклава, Аугментина или Флемоксина. Длительность лечебной терапии в среднем составляет десять дней.
Лечить стрептококк в горле у ребенка гораздо тяжелее. Но в большинстве случаев малыша помещают в стационар, где ему делают уколы с антибиотиками. Если состояние удовлетворительное, то препараты даются в виде суспензии. При этом продолжительность лечения составляет десять-четырнадцать дней. Это нужно для того, чтобы предотвратить осложнения во внутренних органах.
Если у пациента наблюдается аллергическая реакция на пенициллины, то вылечить стрептококк можно при помощи антибиотиков из цефалоспориновой группы в виде Супракса или макролидной группы в виде Эритромицина.
При стрептококке горла у детей в виде скарлатины избавиться от инфекции помогают аминогликозиды. Такое лечение позволяет избежать процесса генерализации.
Чем еще можно лечить стрептококковую инфекцию?
Лечение стрептококка в горле подразумевает выполнение дополнительных мероприятий в виде:
- приема жаропонижающих медикаментов. Они назначаются при температуре выше 38,5 градуса;
- употребления большого количества жидкости. Больной может пить теплую воду, зеленый чай, компоты и морсы. Но стоит помнить о том, что количество не должно быть меньше двух литров в сутки;
- полосканий горла различными антисептическими растворами. Для таких целей отлично подойдет солевой или содовый раствор, травяные настои. Проводить процедуру следует до десяти раз в день;
- рассасывания леденцов и таблеток с антибактериальным и обезболивающим эффектом. Прекрасный эффект оказывают Граммидин, Стрепсилс, Фарингосепт, Лизобакт;
- орошения горла различными средствами в виде Мирамистина, Гексорала, Люголя;
- засыпания в горло антисептических средств в виде стрептоцида;
- ингаляций с физиологическим раствором для смягчения болезненных ощущений и устранения кашля.
Если наблюдается насморк и заложенность носовых ходов, то проводится промывание носовых ходов при помощи солевого или фурацилинового раствора. Также капаются сосудосуживающие средства и местные антибиотики в виде Полидексы или Изофры.
В качестве дополнительного лечения можно использовать народные методы лечения. Вот несколько рецептов.
- Заваривать плоды шиповника или листья малины. Принимать напиток следует до пяти раз в сутки. Оказывает прекрасное жаропонижающее и укрепляющее воздействие.
- Заваривать ромашковый настой с липой. Воздействие напитка заключается в оказании противовоспалительного, жаропонижающего и укрепляющего воздействия. Принимать нужно по три раза в сутки.
Чтобы выздоровление наступило быстрее, нужно отказаться от курения, сладкого и мучного, посещения саун и бани. Затягивать с лечебным процессом нельзя, так как стрептококковая инфекция ведет к серьезнейшим осложнениям. Особенно это касается маленьких детей. Если врач предлагает госпитализировать ребенка, то отказывать от этого не стоит.

При необходимости назначают дезинтоксикационные и антигистаминные средства – «Энтеросгель», «Цетрин».
Абрикосовая мякоть снимает воспаление и восстанавливает слизистую горла;



